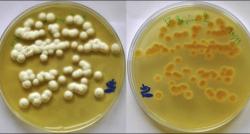

Google şirkəti keçən ilin payız fəslində Google Pixel 7 smartfon seriyası ilə birlikdə həmçinin Pixel Watch smart saatını da...
Texnoloji Xəbərlər
ABŞ-ın “SpaceX” şirkətinə məxsus “Starlink” peyk xidmətləri Azərbaycan ərazisində bu ilin IV rübündə – oktyabr-dekabr aylarında aktivləşəcək.
Bu...
May
18
2023
12:33
Samsung şirkəti 2023-cü ilin birinci rübü üzrə maliyyə hesabatında Exynos prosessorlarının öz flaqman smartfonlarına geri...
May
18
2023
11:14
Münhen Texniki Universitetinin alimləri CO2 qazının daha bir təkrar emal üsulunu fikirləşiblər. Belə ki, alimlər CO2...
May
17
2023
11:14
Apple tədricən öz cihazlarında LCD ekranlardan OLED ekranlara keçid edir. Analitiklər əmindirlər ki, növbəti illərdə şirkət...
May
16
2023
11:46
Microsoft şirkəti süni zəka tapşırıqlarının yerinə yetirilməsi üçün nəzərdə tutulmuş Athena kod adlı fərdi prosessorunu...
May
15
2023
11:33
İnsana bənzər Ameca adlı robot yenidən gündəmə gəlib. Qeyd etmək lazımdır ki, bir neçə il bundan öncə sözügedən robot əsl insan üz...
May
12
2023
11:17
2028-2030-cu illərdə Çin Marsa “Tianwen-3” adlı kosmik missiyanı reallaşdırmağı planlaşdırır. Sözügedən missiyanın əsas məqsədi isə...
May
11
2023
11:18
Keçən il OpenAI şirkəti süni zəka əsaslı GPT-4 dil modelinin mümkün risklərini və üstünlüklərini yoxlamaq üçün 50 nəfər...
May
10
2023
11:26
Honor şirkəti Honor Pad V8 adlı yeni planşetini təqdim edib. Təqdim edilmiş bu yeni planşet böyük ölçülü ekranı, performanslı texniki...
May
08
2023
10:59
Amerikalı milyarder Peter Thiel-ə məxsus olan Palantir adlı şirkət eyniadlı süni zəka platformasını təqdim edib....
May
05
2023
11:16
Bill Qeyts San-Dieqoda keçirilmiş sammitdə çıxış edən zaman generativ süni zəka sistemləri barəsində yeni fikirlərini səsləndirib. O,...
May
04
2023
11:15
Plastik tullantılara Yer kürəsində insanların mövcud olduqları bütün yerlərdə rast gəlmək olar. Təkrar emalı qəliz olan bu material uzun...
May
03
2023
10:39
NVIDIA şirkəti mətn formatında təsvirlər əsasında videolar tərtib edə bilən süni zəka modelini təqdim edib. Sözügedən süni zəka modeli...
May
02
2023
11:34
Bir neçə il bundan öncə İsrailin NSO Group şirkəti geniş məşhurluq qazanmışdı. Belə ki, sözügedən şirkətin, iOS cihazların...
May
01
2023
10:57
İnsayderlərin verdikləri yeni məlumata əsasən Samsung şirkəti qatlana bilən planşet modeli üzərində çalışır. Məlumatda qeyd edilib ki,...
Apr
28
2023
11:06
Huawei və Philips birgə əməkdaşlıq çərçivəsində tamamilə yeni növ cihazı təqdim ediblər. Söhbət, yuxu üçün göz maskası formasında olan...
Apr
27
2023
11:07
Google şirkəti yaxın zamanda öz axtarış sistemi ilə bağlı olan layihələrinin nəticələrini təqdim etməyi planlaşdırır. Qeyd etmək lazımdır ki,...
Apr
26
2023
10:48
Müxtəlif Android versiyalarının istifadəçilər arasında məşhurluqlarını əks etdirən yeni statistika internetdə ortaya çıxıb. Ortaya çıxmış...
Apr
25
2023
11:05
Whatsapp-da yeni funksiyanın testinə start verilib. Söhbət, animasiyalı emojilərdən gedir. Sözügedən funksiya messencerin yeni beta versiyasında...
Apr
21
2023
11:15